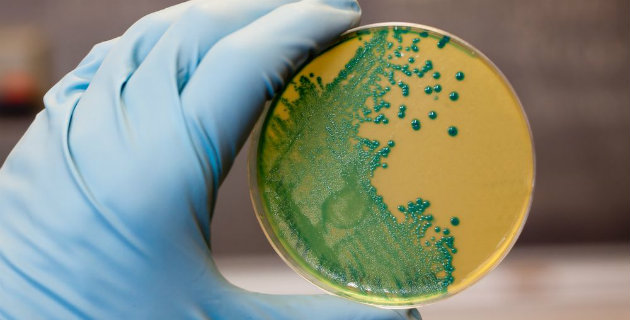

MERS-CoV nedeniyle ölenlerin sayısı 51’e yükseldi
Suudi Arabistan Sağlık Bakanlığından yapılan açıklamada, kronik hastalıkları bulunan iki kişinin daha virüs nedeniyle hayatını kaybetmesiyle ölü sayısının 51’e yükseldiği belirtildi.
Suudi Arabistan’da corona virüsü vakalarına, doğudaki el-Ahsa ve ed-Demmam, kuzeydoğudaki Hafer el-Batın, güneybatıdaki Bişe ve Asir, batıdaki Taif, Cidde, Medine-i Münevvere ile başkent Riyad ve el-Kasım kentlerinde rastlanıyor.
Suudi Arabistan Sağlık Bakanlığı, kutsal topraklara ulaşan hacı adaylarına yapılan tıbbi kontrollerde şu ana kadar “corona” virüsüne rastlanmadığını açıkladı.
Corona virüsü bugüne kadar Suudi Arabistan, Ürdün, Katar, Birleşik Arap Emirlikleri, İngiltere, Fransa, Almanya, Tunus ve İtalya’da tespit edildi.
Eylül 2012’den bu yana 119’u Suudi Arabistan’da olmak üzere dünya genelinde corona ile ilgili 144 vaka tespit edildi. Hastalık nedeniyle 51’i Suudi Arabistan’da olmak üzere şu ana kadar 60 kişi hayatını kaybetti. Suudi Arabistan’da 119, İngiltere’de 4, Ürdün, Fransa ve Almanya’da 2’şer, Tunus, İtalya ve Katar’da 3’er, Birleşik Arap Emirliklerinde 5 vaka ortaya çıktı.
2003 yılında daha çok Asya kıtasında görülen kısa süreli SARS salgınında, 800’den fazla kişi ölmüştü.
Corona virüsü MERS-CoV, akciğerleri ve böbrekleri tahrip ediyor. Bağışıklık sistemini çökerten virüsün uzun süreli yakın temasla bulaşabileceği kaydediliyor. Kaynağı hakkında yeterli bilgi bulunmayan virüse karşı hiçbir koruyucu aşı veya antibiyotik ilaç tedavisi bulunmuyor.